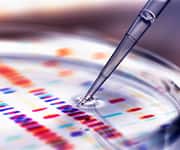

Life Extension Magazine®
In recent years, scientists have established that the accumulation of dysfunctional senescent cells is a factor in the development of degenerative illnesses.1,2
It was not always clear, however, what impact cellular senescence had on brain function.
Published research now indicates that senescent cells play a role in cognitive impairment and disorders such as Alzheimer’s3-5 and Parkinson’s.4,6
Studies in animal models suggest that using compounds called senolytics to eradicate senescent cells from the brain can lead to improvements in brain function and even reverse cognitive deficits.7-9
Several plant-based compounds have been identified that help remove senescent cells from the body.
How Senescent Cells Cause Disease
As cells age and degrade, they’re supposed to die off to make room for new cells. But some don’t, instead becoming dysfunctional and steadily causing damage.
These senescent cells release toxic compounds that damage nearby cells and tissues and incite damaging inflammation.
Cellular senescence is a driver of aging and risk for many age-related chronic diseases.1,2
Studies have examined the kidneys, blood vessels, lungs, bones, and other tissues. In every one of them, cellular senescence has been found to be deleterious. Scientists now know that the brain is no different. It has long been accepted that oxidative stress, inflammation, and abnormal protein deposits all contribute to brain aging and neurodegenerative diseases like Alzheimer’s and Parkinson’s diseases. Now, scientists have added cellular senescence to the list of neurodegenerative contributors.3-6,10
Cellular Senescence and the Brain
The brain is home to several different cell types that work together.
Neurons are the primary nerve cells of the brain that are wired together into synaptic circuits.
Other cells, including astrocytes, microglia, and oligodendrocytes, have important roles such as maintaining the synaptic environment (astrocytes), functioning as the brain’s immune system (microglia), and generating the insulating myelin sheath (oligodendrocytes).
These cells work closely with neurons and are required for normal neurotransmission and synaptic plasticity (the brain’s ability to adapt to new information).11-13
Recent studies suggest that cellular senescence is a culprit in brain aging,3-6 affecting neurons and support cells that make up about 50% of the brain.10
With age, the function of all these brain cells is diminished, leading to lower levels of some neurotransmitters, impaired synaptic signaling, and more. The result is deteriorating brain function and risk for dementias.3-5
For example, preclinical and clinical studies show that abnormal deposits of beta-amyloid plaques associated with Alzheimer’s disease can cause normal brain cells to shift into senescence.14,15 This has been seen in astrocytes, microglia, and oligodendrocytes, which are all critical to neuronal health.16
What You Need To Know
How Senolytics Protect the Brain
- As cells age and accumulate damage, they can enter a state known as cellular senescence. Senescent cells can cause dysfunction and damage throughout the body.
- Senescent cells are a major driver of aging and the development of many age-related chronic diseases.
- Recent research has confirmed that cellular senescence also affects the cells of the brain, including neurons.
- Studies have shown that senescent cells contribute to brain aging and the progression of neurodegenerative disorders like Alzheimer’s disease.
- Senolytics are compounds that are capable of eliminating senescent cells, rejuvenating tissues and improving their function.
- In animal models, senolytic therapy reverses the pathology associated with neurodegenerative disease and improves cognitive function.
Senolytic Approaches
Senolytic compounds are used to help remove senescent cells, slow certain aging processes, and rejuvenate tissues.
The objective is to selectively eliminate senescent cells while not affecting normal, healthy cells. A number of senolytics have shown promise in animal models and a clinical trial. More human trials are underway for a wide range of diseases.1,17
The investigation of senolytics for the management of age-related brain disorders has only recently begun, but has already shown promise.
Multiple preclinical studies have shown that senolytics can effectively remove senescent cells from the brain 7-9 and that this may lead to improvements in cognitive function.
One study done by the National Institute on Aging and the Johns Hopkins University School of Medicine explored a mouse model of Alzheimer’s disease.9 In these animals, cells in the vicinity of amyloid plaques show signs of cellular senescence.
Treating these animals with two senolytics, the cancer drug dasatinib and the plant compound quercetin, eliminated senescent cells, reduced brain inflammation, and lessened the load of amyloid deposits.
Most remarkably, this treatment led to a reversal of cognitive deficits.
Human trials of senolytics in adults with mild cognitive impairment or Alzheimer’s disease are currently underway.18,19 They are also using a dasatinib-quercetin combination, but plant-based senolytics may also prove to have brain-aging fighting benefits.
Summary
Research indicates that senescent cells play a role in brain aging and common brain disorders such as Alzheimer’s.
Senolytic compounds eliminate senescent cells from tissues to slow certain aging processes and reduce degenerative disease risks.
Studies in animal models reveal that senolytics can effectively remove senescent cells from the brain, reversing cognitive deficits.
Plant-Derived Senolytics
Certain plant-derived nutrients have been shown to remove senescent cells from the body.20 They work in different ways and appear to be more powerful together than they are alone.
- Scientists searching for a senolytic plant compound that works in a similar way as dasatinib settled on theaflavins, polyphenols derived from black tea. They act by blocking ephrin receptors, a mechanism they share with dasatinib.22,23
- Quercetin is a flavonoid found in many plants. It displays remarkable senolytic activity alone but has traditionally been used alongside the cancer drug dasatinib.20,21
- Another plant flavonoid, fisetin, is the most potent plant-derived senolytic discovered to date.24,25 It has been shown to be neuroprotective in animal models of Alzheimer’s disease, Parkinson’s disease, and more.
- Apigenin—found in chamomile flowers and other plants—reduces the pro-inflammatory compounds emitted by senescent cells, quenching the fire of chronic inflammation.26,27
A combination of these four nutrients attacks senescent cells from multiple angles.
If you have any questions on the scientific content of this article, please call a Life Extension Wellness Specialist at 1-866-864-3027.
References
- Chaib S, Tchkonia T, Kirkland JL. Cellular senescence and senolytics: the path to the clinic. Nat Med. 2022 Aug;28(8):1556-68.
- Zhang L, Pitcher LE, Yousefzadeh MJ, et al. Cellular senescence: a key therapeutic target in aging and diseases. J Clin Invest. 2022 Aug 1;132(15).
- Guerrero A, De Strooper B, Arancibia-Carcamo IL. Cellular senescence at the crossroads of inflammation and Alzheimer’s disease. Trends Neurosci. 2021Sep;44(9):714-27.
- Martinez-Cue C, Rueda N. Cellular Senescence in Neurodegenerative Diseases. Front Cell Neurosci. 2020;14:16.
- Liu RM. Aging, Cellular Senescence, and Alzheimer’s Disease. Int J Mol Sci. 2022 Feb 11;23(4).
- Lee S, Wang EY, Steinberg AB, et al. A guide to senolytic intervention in neurodegenerative disease. Mech Ageing Dev. 2021 Dec;200:111585.
- Bussian TJ, Aziz A, Meyer CF, et al. Clearance of senescent glial cells prevents tau-dependent pathology and cognitive decline. Nature. 2018 Oct;562(7728):578-82.
- Musi N, Valentine JM, Sickora KR, et al. Tau protein aggregation is associated with cellular senescence in the brain. Aging Cell. 2018 Dec;17(6):e12840.
- Zhang P, Kishimoto Y, Grammatikakis I, et al. Senolytic therapy alleviates Abeta-associated oligodendrocyte progenitor cell senescence and cognitive deficits in an Alzheimer’s disease model. Nat Neurosci. 2019 May;22(5):719-28.
- Sikora E, Bielak-Zmijewska A, Dudkowska M, et al. Cellular Senescence in Brain Aging. Front Aging Neurosci. 2021;13:646924.
- De Luca C, Colangelo A, Virtuoso A, et al. Neurons, Glia, Extracellular Matrix and Neurovascular Unit: A Systems Biology Approach to the Complexity of Synaptic Plasticity in Health and Disease. International Journal of Molecular Sciences. 2020 02/24;21:1539.
- Domingues HS, Portugal CC, Socodato R, et al. Oligodendrocyte, Astrocyte, and Microglia Crosstalk in Myelin Development, Damage, and Repair. Frontiers in Cell and Developmental Biology. 2016 2016-June-28;4.
- Available at: https://qbi.uq.edu.au/brain-basics/brain/brain-physiology/types-glia Accessed March, 24, 2023.
- Bhat R, Crowe EP, Bitto A, et al. Astrocyte senescence as a component of Alzheimer’s disease. PLoS One. 2012;7(9):e45069.
- Walton CC, Begelman D, Nguyen W, et al. Senescence as an Amyloid Cascade: The Amyloid Senescence Hypothesis. Front Cell Neurosci. 2020;14:129.
- Han X, Zhang T, Liu H, et al. Astrocyte Senescence and Alzheimer’s Disease: A Review. Front Aging Neurosci. 2020;12:148.
- Tchkonia T, Palmer AK, Kirkland JL. New Horizons: Novel Approaches to Enhance Healthspan Through Targeting Cellular Senescence and Related Aging Mechanisms. J Clin Endocrinol Metab. 2021 Mar 8;106(3):e1481-e7.
- Available at: https://clinicaltrials.gov/ct2/show/NCT04785300. Accessed October 25, 2022,
- Available at: https://clinicaltrials.gov/ct2/show/NCT04685590. Accessed October 25, 2022,
- Kirkland JL, Tchkonia T. Senolytic drugs: from discovery to translation. J Intern Med. 2020 Nov;288(5):518-36.
- Kim SR, Jiang K, Ogrodnik M, et al. Increased renal cellular senescence in murine high-fat diet: effect of the senolytic drug quercetin. Transl Res. 2019 Nov;213:112-23.
- Han X, Zhang J, Xue X, et al. Theaflavin ameliorates ionizing radiation-induced hematopoietic injury via the NRF2 pathway. Free Radic Biol Med. 2017 Dec;113:59-70.
- Noberini R, Koolpe M, Lamberto I, et al. Inhibition of Eph receptor-ephrin ligand interaction by tea polyphenols. Pharmacol Res. 2012 Oct;66(4):363-73.
- Yousefzadeh MJ, Zhu Y, McGowan SJ, et al. Fisetin is a senotherapeutic that extends health and lifespan. EBioMedicine. 2018 Oct;36:18-28.
- Zhu Y, Doornebal EJ, Pirtskhalava T, et al. New agents that target senescent cells: the flavone, fisetin, and the BCL-X(L) inhibitors, A1331852 and A1155463. Aging (Albany NY). 2017 Mar 8;9(3):955-63.
- Lim H, Park H, Kim HP. Effects of flavonoids on senescence-associated secretory phenotype formation from bleomycin-induced senescence in BJ fibroblasts. Biochem Pharmacol. 2015 Aug 15;96(4):337-48.
- Perrott KM, Wiley CD, Desprez PY, et al. Apigenin suppresses the senescence-associated secretory phenotype and paracrine effects on breast cancer cells. Geroscience. 2017 Apr;39(2):161-73.